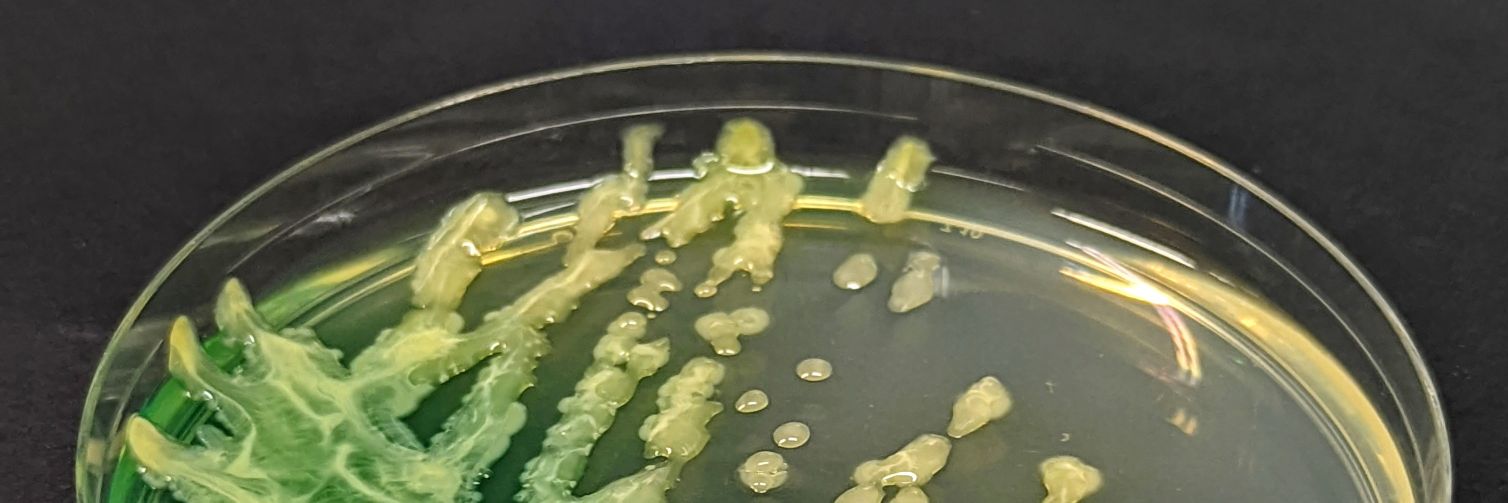
Dr. Matthew Shepherd banner

Dr. Matthew Shepherd
1.4K posts

Dr. Matthew Shepherd
@MicrobialMatts
migrating to 🟦☁️🦋 @matthewjshepherd Postdoc @OfficialUoM with @BrockhurstLab. Understanding and predicting the evolution of antimicrobial resistance 🔬🦠
Manchester, England Katılım Temmuz 2019
850 Takip Edilen1.2K Takipçiler
Henüz tweet yok